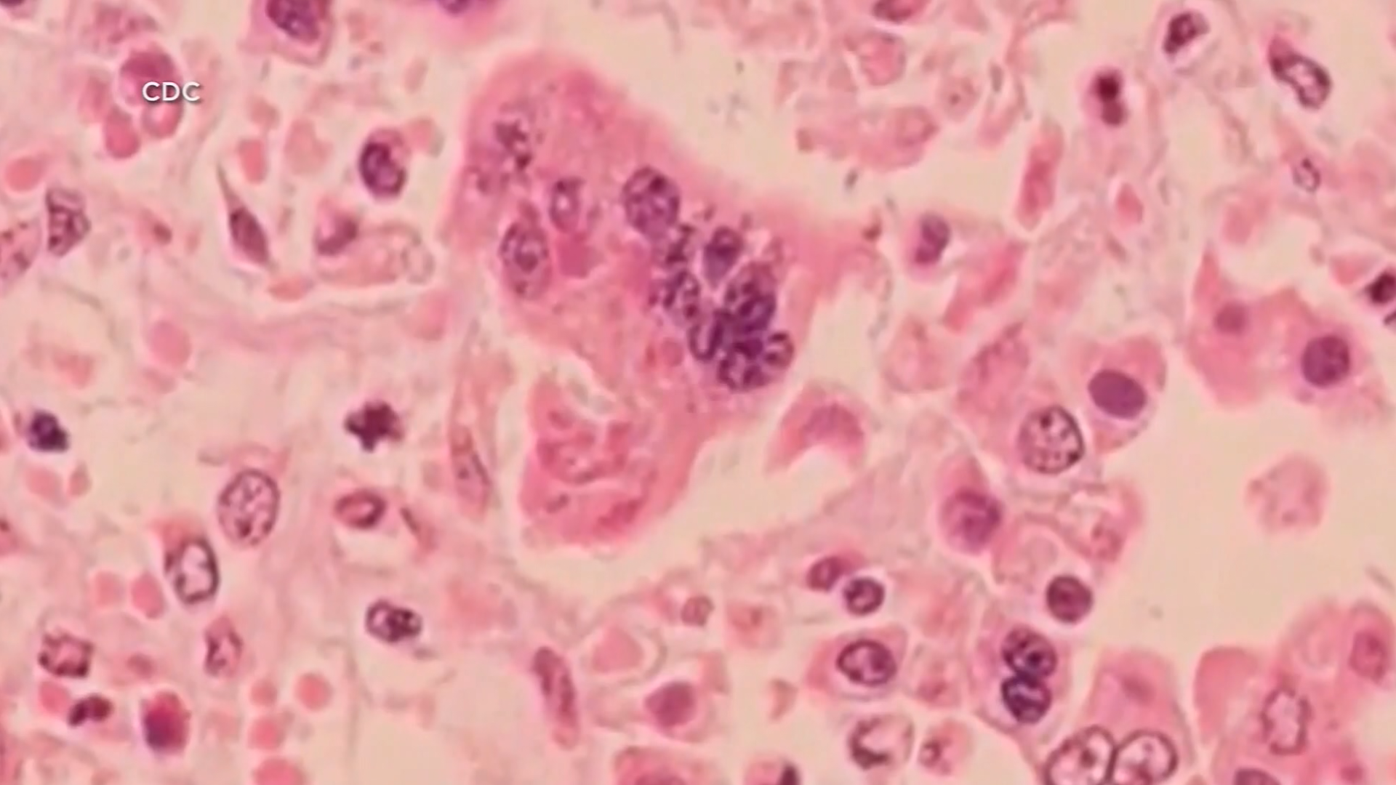
57 Cases of Measles Confirmed at Ave Maria University, 7 Currently Contagious

Ave Maria University in southwestern Florida has been hit with a measles outbreak, with a total of 57 cases confirmed among students and staff. The outbreak was first reported on February 27 and has since prompted concern among parents and students alike.
The 7 students who are currently contagious are reportedly being treated by the university's health services team. The university has taken measures to contain the outbreak, including isolating infected students and increasing vaccination efforts among the student body.
Measles is a highly contagious disease that can spread through the air when an infected person coughs or sneezes. The disease can also be spread through contact with someone who has the virus, even if that person is not showing symptoms.
Response Efforts Underway
The university has been working closely with local health officials and the CDC to contain the outbreak and prevent further spread of the disease. The university's health services team has been providing treatment and support to infected students, while also conducting contact tracing to identify individuals who may have been exposed to the virus.
The CDC has also been providing guidance and support to the university and local health officials, including recommendations for vaccination efforts and outbreak response strategies.
Ave Maria University has a vaccination policy in place, which requires students to provide proof of vaccination against measles before enrolling. However, some students may have been exempt from vaccination due to medical or religious reasons.
Concerns Raised Over Vaccine Exemptions
Measles Outbreak Sparks Debate Over Vaccine Exemptions
Summary: The measles outbreak at Ave Maria University has raised concerns over vaccine exemptions and the importance of vaccination in preventing the spread of the disease. The university's policy on vaccine exemptions has come under scrutiny, with some arguing that it creates a risk for students who are not vaccinated.
The measles outbreak at Ave Maria University has sparked a heated debate over vaccine exemptions and the importance of vaccination in preventing the spread of the disease. The university's policy on vaccine exemptions has come under scrutiny, with some arguing that it creates a risk for students who are not vaccinated.
Under the university's policy, students who have medical or religious objections to vaccination are allowed to opt out of vaccination requirements. However, critics argue that this policy creates a "vaccine gap" that allows the disease to spread among unvaccinated students.
The CDC and other health experts have long argued that vaccination is the most effective way to prevent the spread of measles and other preventable diseases. In fact, the CDC recommends that all children receive two doses of the measles, mumps, and rubella (MMR) vaccine to protect against measles.
Impact on Student Health and Safety
The measles outbreak at Ave Maria University has had a significant impact on student health and safety. In addition to the 57 confirmed cases of measles, the outbreak has also raised concerns over the spread of other preventable diseases.
The university's health services team has been working to contain the outbreak and prevent further spread of the disease. However, some students have expressed concerns over the university's response to the outbreak and the effectiveness of its vaccination policy.
As the outbreak continues to unfold, the university and local health officials are working to identify the source of the outbreak and prevent further spread of the disease.
Measles is a highly contagious disease that can spread through the air when an infected person coughs or sneezes. The disease can also be spread through contact with someone who has the virus, even if that person is not showing symptoms.
Long-Term Consequences of the Outbreak
The measles outbreak at Ave Maria University has had long-term consequences for the university and the wider community. The outbreak has raised concerns over the effectiveness of the university's vaccination policy and the impact of vaccine exemptions on student health and safety.
The outbreak has also highlighted the importance of vaccination in preventing the spread of preventable diseases. As the university and local health officials continue to work to contain the outbreak, the long-term consequences of the outbreak remain a concern.
The CDC and other health experts will be closely monitoring the situation and providing guidance and support to the university and local health officials to prevent further spread of the disease.
As the outbreak continues to unfold, it is clear that the measles outbreak at Ave Maria University has significant implications for student health and safety and highlights the importance of vaccination in preventing the spread of preventable diseases.
The measles outbreak at Ave Maria University has sparked a heated debate over vaccine exemptions and the importance of vaccination in preventing the spread of the disease. The university's policy on vaccine exemptions has come under scrutiny, with some arguing that it creates a risk for students who are not vaccinated.
Under the university's policy, students who have medical or religious objections to vaccination are allowed to opt out of vaccination requirements. However, critics argue that this policy creates a "vaccine gap" that allows the disease to spread among unvaccinated students.
The CDC and other health experts have long argued that vaccination is the most effective way to prevent the spread of measles and other preventable diseases. In fact, the CDC recommends that all children receive two doses of the measles, mumps, and rubella (MMR) vaccine to protect against measles.
Impact on Student Health and Safety
The measles outbreak at Ave Maria University has had a significant impact on student health and safety. In addition to the 57 confirmed cases of measles, the outbreak has also raised concerns over the spread of other preventable diseases.
The university's health services team has been working to contain the outbreak and prevent further spread of the disease. However, some students have expressed concerns over the university's response to the outbreak and the effectiveness of its vaccination policy.
As the outbreak continues to unfold, the university and local health officials are working to identify the source of the outbreak and prevent further spread of the disease.
Measles is a highly contagious disease that can spread through the air when an infected person coughs or sneezes. The disease can also be spread through contact with someone who has the virus, even if that person is not showing symptoms.
Long-Term Consequences of the Outbreak
The measles outbreak at Ave Maria University has had long-term consequences for the university and the wider community. The outbreak has raised concerns over the effectiveness of the university's vaccination policy and the impact of vaccine exemptions on student health and safety.
The outbreak has also highlighted the importance of vaccination in preventing the spread of preventable diseases. As the university and local health officials continue to work to contain the outbreak, the long-term consequences of the outbreak remain a concern.
The CDC and other health experts will be closely monitoring the situation and providing guidance and support to the university and local health officials to prevent further spread of the disease.
As the outbreak continues to unfold, it is clear that the measles outbreak at Ave Maria University has significant implications for student health and safety and highlights the importance of vaccination in preventing the spread of preventable diseases.